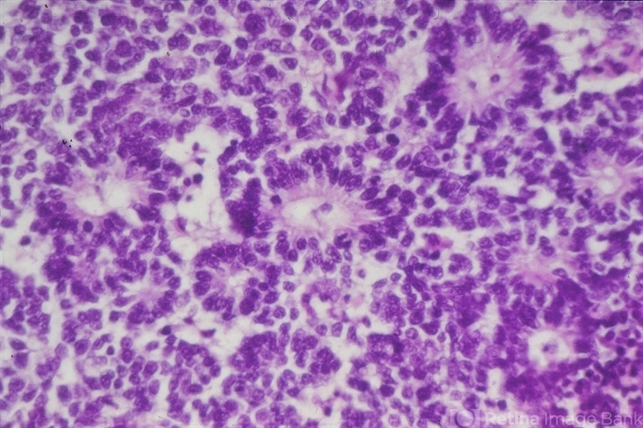
file

-
 By McGill University Health Centre
By McGill University Health Centre
The MUHC-McGill University
Co-author(s): Miguel N. Burnier, McGill University Health Center-McGill University Ocular Pathology & Translational Research Laboratory - Uploaded on Oct 9, 2019.
- Last modified by Caroline Bozell on Oct 11, 2019.
- Rating
- Appears in
- Retinoblastoma
- Condition/keywords
- retinoblastoma, Flexner-Wintersteiner rosettes, histopathology
- Photographer
- Miguel N. Burnier, McGill University Health Center-McGill University Ocular Pathology & Translational Research Laboratory
- Description
- Bilateral retinoblastoma in a 3-month-old baby boy . High power field of retinoblastoma showing multiple rosettes.

Initializing download.
Initializing download.



---thumb.jpg/image-square;max$79,0.ImageHandler)





---thumb.jpg/image-square;max$79,0.ImageHandler)
